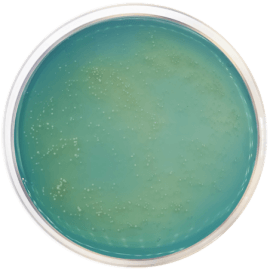
main product photo

Close
BRETTANOMYCESS AGAR 500 grams/bottle
SKU
CDL/2006
Brand
CONDALAB
Pre-order (Deliver in 8 to 12 weeks)
Brettanomyces Agar is a medium used for cultivation of Brettanomyces of wines.
Brettanomyces is a genus of yeast capable of growing in high concentrations of alcohol and of fermenting sugars that have not been used by Saccharomyces cerevisiae during fermentation. The presence of Brettanomyces is associated with the appearance of strange wine aromas due to the production of 4-ethyl guaiacol and 4-ethyl phenol.
Brettanomyces is also called Dekkera (name given to species with sexual reproduction and therefore, formation of spores by meiosis). It is generally found in red wines in barrels or bulk storage. since acids necessary to form some of the indicative aromas are extracted from grape skins, but infections have also been found in Chardonnay and Sauvignon Blanc.
Dextrose is the fermentable carbohydrate providing carbon and energy. Peptone and malt extract provide nitrogen, vitamins, minerals, and amino acids essential for growth. Yeast extract is source of vitamins, particularly the B group. Thiamine is a growth factor. Selective agents are added to improve Brettanomyces recovery through the inhibition of common contaminants as Saccharomyces cerevisiae.
Brettanomyces Agar is a medium used for cultivation of Brettanomyces of wines.
Brettanomyces is a genus of yeast capable of growing in high concentrations of alcohol and of fermenting sugars that have not been used by Saccharomyces cerevisiae during fermentation. The presence of Brettanomyces is associated with the appearance of strange wine aromas due to the production of 4-ethyl guaiacol and 4-ethyl phenol.
Brettanomyces is also called Dekkera (name given to species with sexual reproduction and therefore, formation of spores by meiosis). It is generally found in red wines in barrels or bulk storage. since acids necessary to form some of the indicative aromas are extracted from grape skins, but infections have also been found in Chardonnay and Sauvignon Blanc.
Dextrose is the fermentable carbohydrate providing carbon and energy. Peptone and malt extract provide nitrogen, vitamins, minerals, and amino acids essential for growth. Yeast extract is source of vitamins, particularly the B group. Thiamine is a growth factor. Selective agents are added to improve Brettanomyces recovery through the inhibition of common contaminants as Saccharomyces cerevisiae.
| Brand | CONDALAB |
|---|
Write Your Own Review

Validate your login